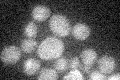
YAL040C
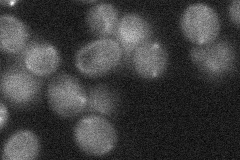
YAL040C

View description
G1 cyclin involved in cell cycle progression; activates Cdc28p kinase to promote the G1 to S phase transition; plays a role in regulating transcription of the other G1 cyclins, CLN1 and CLN2; regulated by phosphorylation and proteolysis
Localization:
Intensity:
Fold change:
Significance:
-
C’ GFP library in SD
below threshold16.28 -
N' NOP1pr-GFP in SD

below threshold0 -
N' TEF2pr-mCherry in SD

below threshold4.6097 -
N' NATIVEpr-GFP in SD
below threshold21.2146 -
N' TEF2pr-VC and Cyto-VN in SD

#N/A0 -
C’ GFP library in SD+DTT

cytosol16.611.01No -
C’ GFP library in SD+H2O2

cytosol19.951.22No -
C’ GFP library in Starvation Media

cytosol14.730.9No -
C’ GFP library on the background of Pup2-DaMP

below threshold -
C’ GFP library on the background of CCT mutant

below threshold18.25121.12042No
